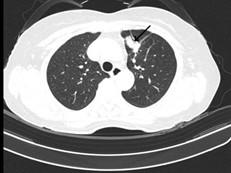

Ca lâm sàng:
Hiệu quả điều trị đích bằng Osimertinib ở bệnh nhân ung thư biểu mô tuyến của phổi giai đoạn IV có đột biến gen EGFR L858R (Exon 21) tại Trung tâm Y học hạt nhân và Ung bướu – Bệnh viện Bạch Mai
GS.TS Mai Trọng Khoa, PGS. TS. Phạm Cẩm Phương, Ths.BSCKII.Lê Viết Nam, SV. Đinh Thị Thu Thảo
Trung tâm Y học hạt nhân và Ung bướu – Bệnh viện Bạch Mai
Trường Đại học Y Dược – Đại học Quốc Gia Hà Nội
Ung thư phổi là một trong những ung thư có tỷ lệ mắc và tử vong cao nhất trên toàn thế giới. Theo GLOBOCAN 2022, ung thư phổi đứng thứ hai về số ca mắc mới với khoảng 2,5 triệu trường hợp mỗi năm và là nguyên nhân hàng đầu gây tử vong do ung thư với hơn 1,8 triệu ca[1]. Ung thư phổi không tế bào nhỏ chiếm khoảng 80% các trường hợp, trong đó ung thư biểu mô tuyến là thể thường gặp. Đột biến EGFR (Epidermal Growth Factor Receptor) gặp ở khoảng 25–30% bệnh nhân ung thư biểu mô tuyến phổi, phổ biến nhất là mất đoạn exon 19 và đột biến L858R trên exon 21, thường gặp ở nữ, lớn tuổi[2]. Sự xuất hiện của các thuốc ức chế tyrosine kinase nhắm trúng đích EGFR đã làm thay đổi lớn tới hiệu quả và tiên lượng điều trị của bệnh nhân[3]. Trong đó, Osimertinib là EGFR -TKI thế hệ ba, cho thấy hiệu quả điều trị vượt trội, ít độc tính và đem lại an toàn cao hơn so với các thế hệ trước[4].
Sự phát triển của kỹ thuật giải trình tự gen thế hệ mới (Next Generation Sequencing – NGS) giúp nhận diện chính xác đột biến và phát hiện thêm các dạng đột biến hiếm, góp phần tối ưu hóa việc cá thể hóa điều trị. Dưới đây là ca lâm sàng ung thư biểu mô tuyến của phổi di căn, đột biến EGFR L858R (Exon 21), đáp ứng tốt với Osimertinib, nhằm nhấn mạnh vai trò quan trọng của liệu pháp nhắm trúng đích trong điều trị ung thư phổi hiện nay.
Họ và tên: ĐỖ T. N. Giới tính: Nữ Tuổi: 73
Nghề nghiệp: Hưu trí
Lý do vào viện: Đau vai gáy
Tiền sử:
- Bản thân: Khỏe mạnh
- Gia đình: Chưa ghi nhận bệnh lý liên quan
Bệnh sử: Tháng 4/2025 bệnh nhân xuất hiện triệu chứng đau mỏi vai gáy, đau ngực trái kèm ho khan, không mệt mỏi, ăn uống bình thường, không gầy sút cân. Đi khám tại Bệnh viện Đa khoa Thái Bình, được chỉ định chụp cắt lớp vi tính lồng ngực: Hình ảnh u thùy trên phổi trái kích thước 40×27 mm, nhu mô còn lại rải rác các mờ, theo dõi thứ phát. Hạch trung thất, tràn dịch màng phổi trái 60mm. Hình ảnh tiêu đầu xương trong xương đòn trái, vào Trung tâm Y học hạt nhân và Ung bướu, Bệnh viện Bạch Mai được điều trị Osimertinib. Bệnh nhân được nhập viện đánh giá.
Khám lâm sàng:
- Bệnh nhân tỉnh, tiếp xúc tốt
- Toàn trạng: PS 1
- Thể trạng: Trung bình, Chiều cao: 155cm , Cân nặng: 50kg, BMI: 20.81kg/m2.
- Da niêm mạc hồng, huyết động ổn định
- Hạch ngoại vi không sờ thấy
- Bụng mềm, không có phản ứng thành bụng.
- Tim đều, T1, T2 rõ, không có tiếng thổi bất thường
- Phổi rì rào phế nang rõ, không rales
- Không có triệu chứng của các cơ quan khác
Xét nghiệm cận lâm sàng trước điều trị
- Xét nghiệm: Công thức máu, chức năng gan thận, điện giải đồ trong giới hạn bình thường, HIV âm tính, HBsAg âm tính, HCV âm tính.
- Xét nghiệm chất chỉ điểm khối u: CEA: 533.3 ng/mL (tăng rất cao)
- Siêu âm hạch vùng cổ: Hình ảnh hạch thượng đòn, không rõ rốn, kích thước 9x5mm
- Cắt lớp vi tính ngực (Bệnh viện Bạch Mai): Phổi trái: Phân thùy S3 có khối tỷ trọng tổ chức kích thước 24x15mm, ngấm thuốc sau tiêm bờ không đều xâm lấn vào màng phổi trung thất, động mạch, tĩnh mạch phổi trái gây huyết khối bán phần. Xẹp thụ động thùy dưới. Màng phổi trái: có nốt ngấm thuốc đường kính 8mm. Dịch khoang màng phổi trái dày 60mm gây xẹp thụ động thùy dưới. Hạch trung thất nhóm V, nhóm II, IV bên phải và carina lớn nhất kích thước 23x12mm. Hình ảnh tổn thương tiêu xương đòn trái.

Hình 1: Hình ảnh cắt lớp vi tính ngực lúc mới nhập viện: Khối tổn thương thùy trên phổi trái, tỷ trọng tổ chức, bờ không đều, ngấm thuốc không đồng nhất, xâm lấn màng phổi trung thất (mũi tên màu đỏ). Tràn dịch màng phổi trái lượng nhiều gây xẹp phổi thụ động thùy dưới (mũi tên màu vàng).
- Cộng hưởng từ sọ não: Nhu mô bán cầu tiểu não trái và thuỳ đỉnh trái cạnh thể trai có tổn thương tăng tín hiệu trên FLAIR, ngấm thuốc viền sau tiêm, phù não rộng xung quanh, kích thước 11x12mm và 7mm (theo dõi thứ phát). Nhu mô chất trắng cạnh não thất bên và trung tâm bán bầu dục hai bên có vài nốt thoái hoá myelin chất trắng, đường kính <5mm

Hình 2: Cộng hưởng từ sọ não lúc mới nhập viện: Tổn thương tăng tín hiệu trên FLAIR tại bán cầu tiểu não trái và thùy đỉnh trái cạnh não thất(mũi tên đỏ).
- Chụp cắt lớp vi tính bụng: Hình ảnh nang gan, nang thận hai bên.
- Xét nghiệm tế bào học dịch màng phổi: Hướng tới Ung thư biểu mô tuyến di căn
- Sinh thiết dịch màng phổi: Hình ảnh mô bệnh học và hoá mô miễn dịch phù hợp với Ung thư biểu mô tuyến của phổi di căn.
- Xét nghiệm đột biến gen EGFR: Phát hiện đột biến L858R trên exon 21 gen EGFR.
- Xét nghiệm giải trình tự gen bằng kỹ thuật giải trình tự gen thế hệ 2: Phát hiện biến thể p.L858R (c.2573T>G) trên exon 21 gen EGFR.
Chẩn đoán xác định: Ung thư biểu mô tuyến của phổi trái cT4N2M1 giai đoạn IV (xương đòn, não), EGFR (+).
Hướng xử trí: Bệnh nhân được hội chẩn hội đồng chuyên môn, được chỉ định điều trị bằng phác đồ điều trị đích: Osimertinib 80mg/ngày, uống 1 viên buổi sáng.
Đánh giá lại sau 3 tháng điều trị đích:
- Về lâm sàng: Bệnh nhân không đau ngực, không khó thở, làm việc và sinh hoạt được, gầy sút 4kg trong vòng 2 tháng.
- Chất chỉ điểm khối u (Tumor marker): CEA: 8.89 ng/mL.
- Cắt lớp vi tính ngực (Bệnh viện Bạch Mai): phổi trái: phân thùy S3 có khối tỷ trọng tổ chức kích thước 18x26mm, bờ không đều ranh giới không rõ với màng phổi trung thất, lân cận có vài dải xẹp. Nốt bán đặc nhỏ thùy dưới đường kính khoảng 4mm. Vài hạch trung thất đường kính <10mm. Xương đòn trái có đậm độ không đều kèm dày vỏ xương đoạn 1/3 trong. Khoang màng phổi hai bên không thấy dịch – khí.
Hình 3: Cắt lớp vi tính lồng ngực sau 3 tháng điều trị bằng Osimertinib cho thấy khối u phổi trái tại phân thùy S3 giảm kích thước (mũi tên đen), hạch trung thất thoái triển, tràn dịch màng phổi giảm.
Đánh giá lại sau 6 tháng điều trị đích
- Về lâm sàng: Bệnh nhân không đau ngực, không khó thở, làm việc và sinh hoạt được, không gầy sút cân.
- Chất chỉ điểm khối u: CEA: 1.65 ng/mL (giảm về giới hạn bình thường).
- Chụp MRI sọ não có tiêm thuốc cản quang: Hình ảnh thoái hóa myelin quanh não thất bên và trung tâm bán bầu dục hai bên. Dày nhẹ niêm mạc xoang sàng hai bên. Hiện không thấy nốt ngấm thuốc bất thường nhu mô não.

Hình 4: MRI sọ não sau tiêm thuốc cho thấy các ổ thoái hóa myelin rải rác vùng chất trắng, không ghi nhận tổn thương ngấm thuốc bất thường nhu mô não.
Nhận xét: Sau 3 tháng điều trị đích bằng Osimertinib (80mg/ngày), bệnh nhân ghi nhận đáp ứng điều trị rõ rệt. Lâm sàng cải thiện tốt. Trên cắt lớp vi tính lồng ngực, khối u phổi trái giảm kích thước, hạch trung thất thoái triển, tràn dịch màng phổi giảm đáng kể. Theo tiêu chuẩn RECIST 1.1, bệnh nhân được đánh giá đáp ứng 1 phần. Sau 6 tháng điều trị đích, bệnh nhân cải thiện rõ về mặt lâm sàng, toàn trạng ổn, xét nghiệm chất chỉ điểm khối u giảm rõ rệt, cắt lớp vi tính bụng, não không ghi nhận tổn thương thứ phát. Kết quả cho thấy hiệu quả kiểm soát bệnh kéo dài của Osimertinib.
Bàn luận
Liệu pháp điều trị đích ngày càng đóng vai trò quan trọng trong điều trị ung thư biểu mô tuyến của phổi, EGFR (+). Việc phát hiện đột biến sớm có ý nghĩa quyết định trong lựa chọn hướng điều trị. Bệnh nhân trong ca lâm sàng này được lựa chọn điều trị Osimertinib 80mg/ngày ngay từ đầu đã mang lại đáp ứng điều trị sớm và rõ rệt. Sau 3 tháng điều trị, bệnh nhân đáp ứng một phần theo tiêu chuẩn RECIST 1.1 với sự thu nhỏ khối u nguyên phát, thoái triển hạch trung thất, tràn dịch màng phổi giảm đáng kể. Sau 6 tháng điều trị, bệnh nhân tiếp tục duy trì đáp ứng lâm sàng ổn định, không còn ghi nhận tổn thương ngấm thuốc bất thường, tổn thương xương ổn định, cho thấy hiệu quả kiểm soát tổn thương hệ thần kinh trung ương và di căn xương của Osimertinib. Trong quá trình điều trị, bệnh nhân ghi nhận sụt cân mức độ nhẹ, không ghi nhận các tác dụng phụ thường gặp như tiêu chảy, ban da mức độ nặng, không cần giảm liều hay gián đoạn điều trị. Kết quả của ca lâm sàng này phù hợp với kết quả nghiên cứu FLAURA, cho thấy Osimertinib cải thiện đáng kể thời gian sống thêm không tiến triển và khả năng kiểm soát tổn thương hệ thần kinh trung ương so với EGFR-TKI thế hệ trước[4]. Thông qua ca bệnh này, nhấn mạnh vai trò của xét nghiệm sinh học phân tử trong cá thể hóa điều trị và khẳng định hiệu quả, tính an toàn của Osimertinib trong thực hành lâm sàng.




